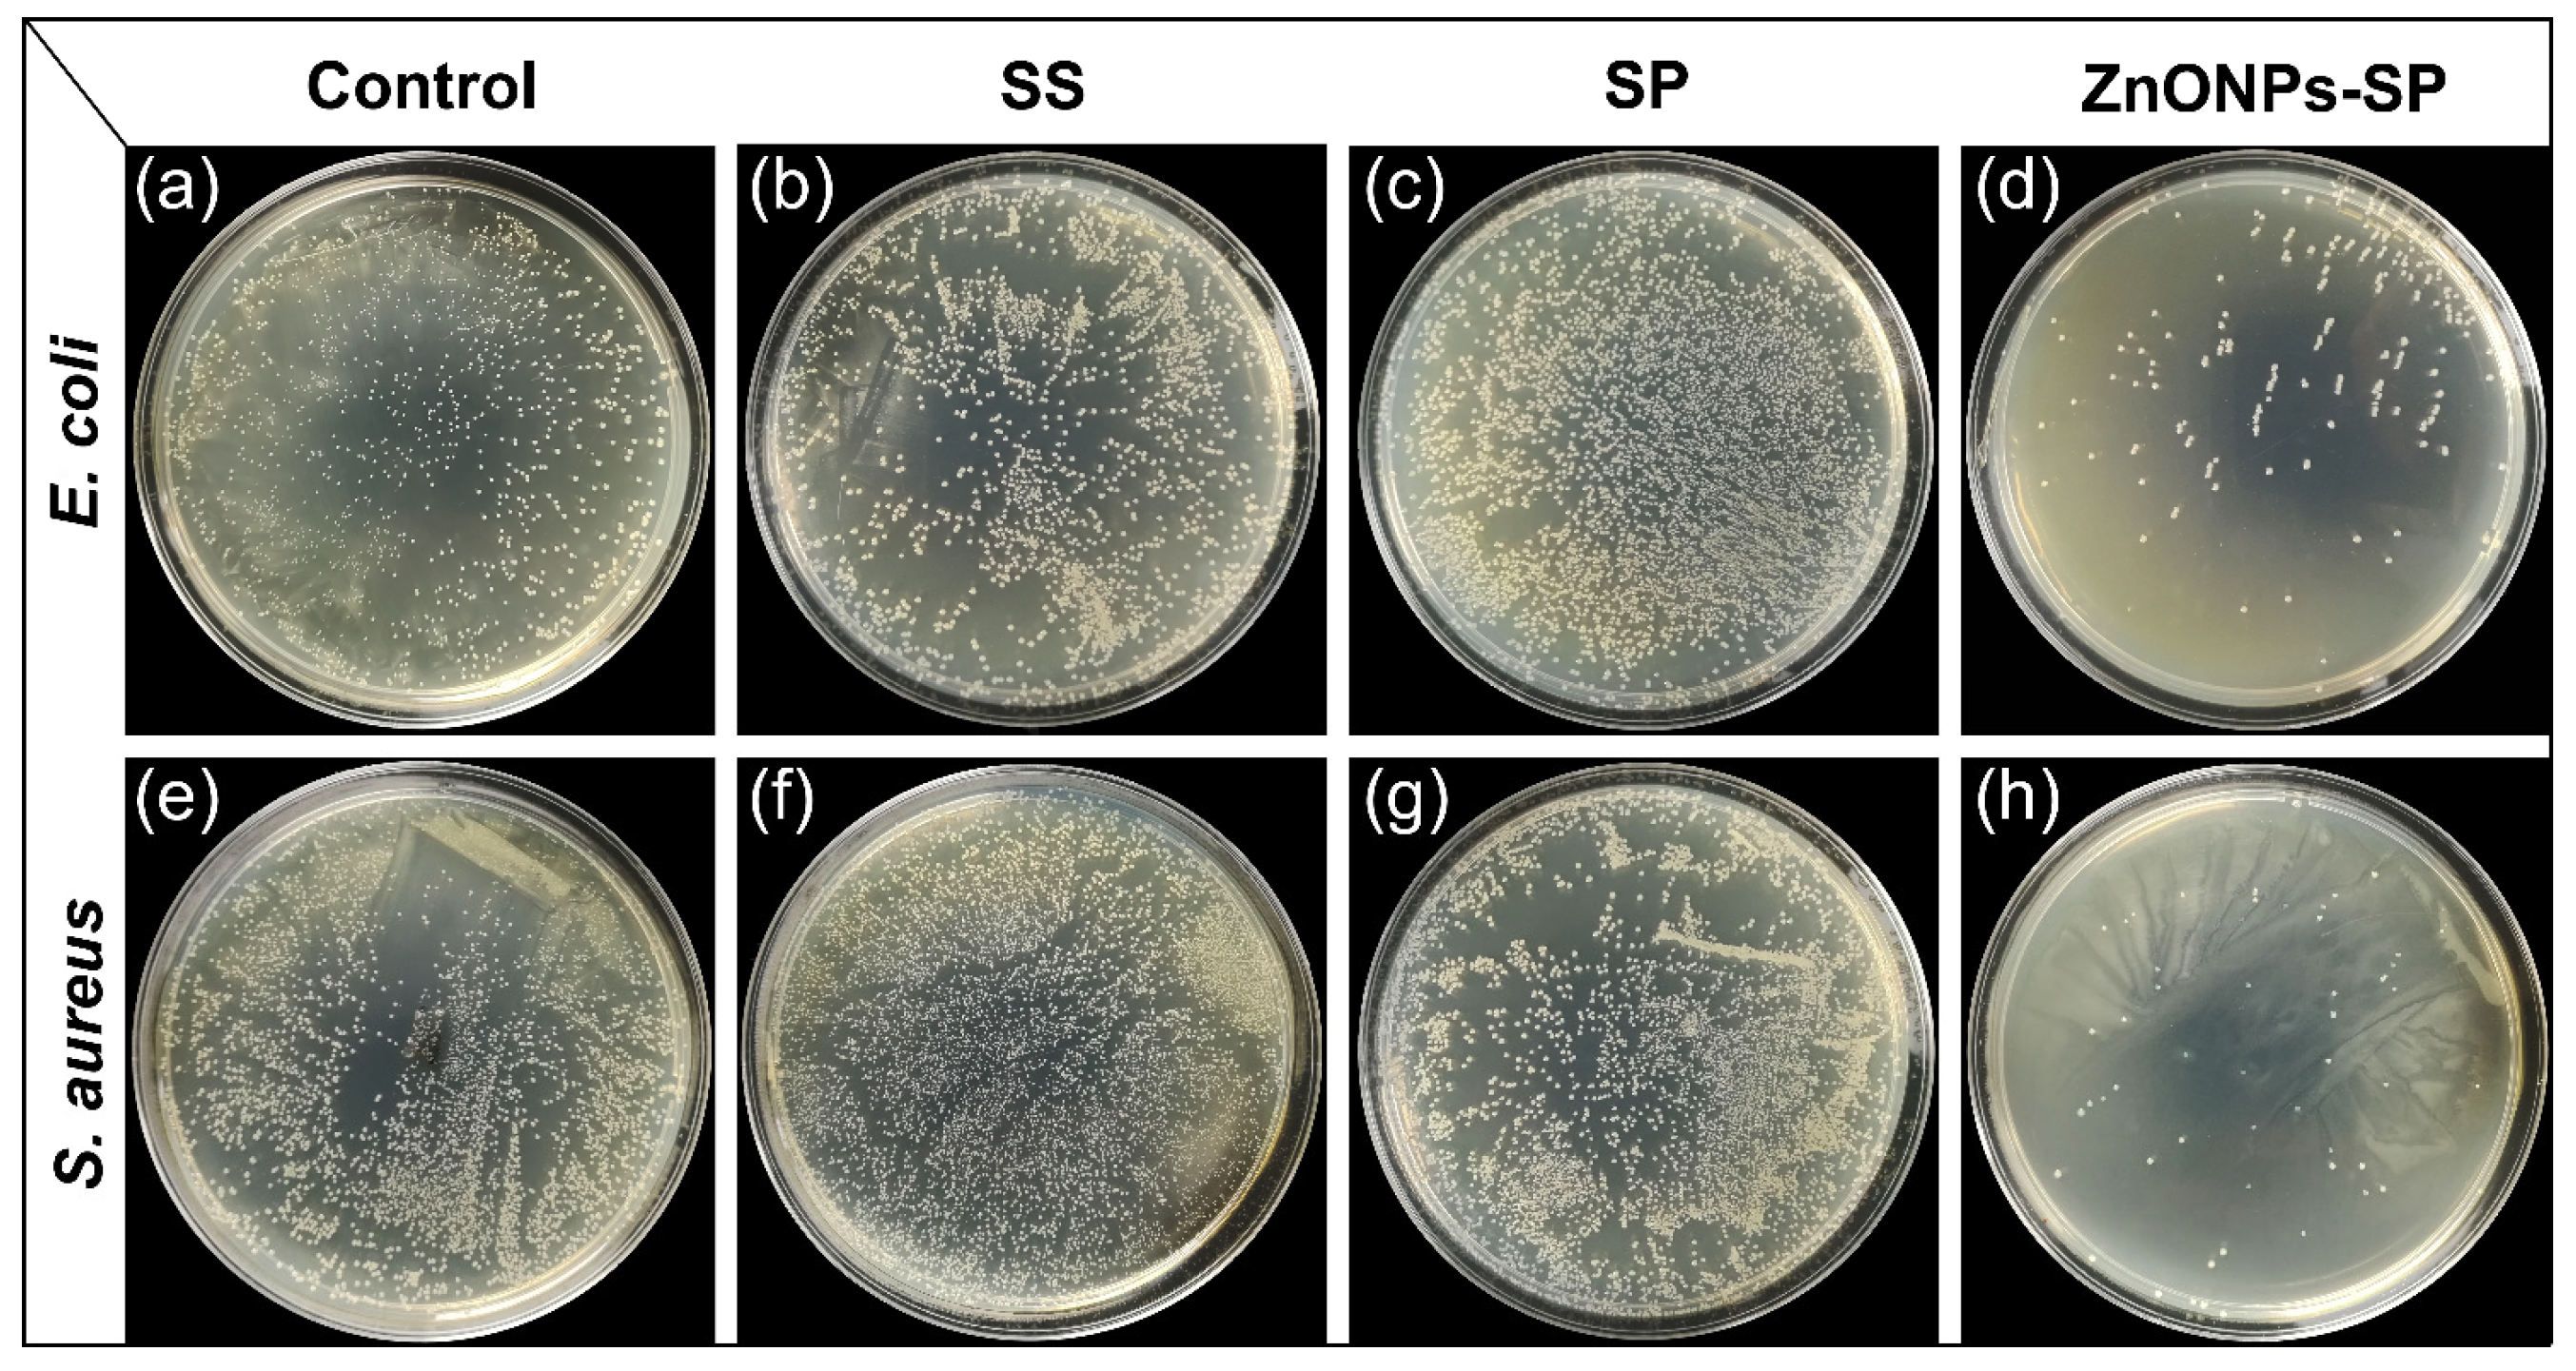
Ijms 20 04796 g006 Ijms 20 04796 g006

Rational Design and Fabrication of ZnONPs Functionalized Sericin/PVA Antimicrobial Sponge
Abstract
1. Introduction
2. Results
2.1. SEM, XRD, FTIR
2.2. Porosity and Swelling Ratio
2.3. Antibacterial Properties
2.4. Cytocompatibility
3. Discussion
4. Materials and Methods
4.1. Materials
4.2. Preparation of ZnONPs-SP Sponge
4.3. Characterization of ZnONPs-SP Sponge
4.4. Porosity and Swelling Ratio
4.5. Antibacterial Assay
4.6. Cell Compatibility
5. Conclusions
Author Contributions
Funding
Conflicts of Interest
References
- Xiao, Y.; Rong, L.; Wang, B.; Mao, Z.; Xu, H.; Zhong, Y.; Zhang, L.; Sui, X. A light-weight and high-efficacy antibacterial nanocellulose-based sponge via covalent immobilization of gentamicin. Carbohydr. Polym. 2018, 200, 595–601. [Google Scholar] [CrossRef] [PubMed]
- Hajipour, M.J.; Mehrani, M.; Abbasi, S.H.; Amin, A.; Kassaian, S.E.; Garbern, J.C.; Caracciolo, G.; Zanganeh, S.; Chitsazan, M.; Aghaverdi, H.; et al. Nanoscale Technologies for Prevention and Treatment of Heart Failure: Challenges and Opportunities. Chem. Rev. 2019. [Google Scholar] [CrossRef] [PubMed]
- Zafar, M.S.; Alnazzawi, A.A.; Alrahabi, M.; Fareed, M.A.; Najeeb, S.; Khurshid, Z. Nanotechnology and nanomaterials in dentistry. In Advanced Dental Biomaterials; Woodhead Publishing: Cambridge, UK, 2019; pp. 477–505. [Google Scholar]
- Tay, A.; Melosh, N. Nanostructured Materials for Intracellular Cargo Delivery. Acc. Chem. Res. 2019. [Google Scholar] [CrossRef] [PubMed]
- Holland, C.; Terry, A.E.; Porter, D.; Vollrath, F. Natural and unnatural silks. Polymer 2007, 48, 3388–3392. [Google Scholar] [CrossRef]
- Wang, P.; He, H.; Cai, R.; Tao, G.; Yang, M.; Zuo, H.; Umar, A.; Wang, Y. Cross-linking of dialdehyde carboxymethyl cellulose with silk sericin to reinforce sericin film for potential biomedical application. Carbohydr. Polym. 2019, 212, 403–411. [Google Scholar] [CrossRef] [PubMed]
- Liu, L.; Cai, R.; Wang, Y.; Tao, G.; Ai, L.; Wang, P.; Yang, M.; Zuo, H.; Zhao, P.; He, H. Polydopamine-Assisted Silver Nanoparticle Self-Assembly on Sericin/Agar Film for Potential Wound Dressing Application. Int. J. Mol. Sci. 2018, 19, 2875. [Google Scholar] [CrossRef] [PubMed]
- Lamboni, L.; Gauthier, M.; Yang, G.; Wang, Q. Silk sericin: A versatile material for tissue engineering and drug delivery. Biotechnol. Adv. 2015, 33, 1855–1867. [Google Scholar] [CrossRef]
- Lalit Jajpura, A.R. The Biopolymer Sericin: Extraction and Applications. J. Text. Sci. Eng. 2015, 5. [Google Scholar] [CrossRef]
- Tao, G.; Cai, R.; Wang, Y.; Liu, L.; Zuo, H.; Zhao, P.; Umar, A.; Mao, C.; Xia, Q.; He, H. Bioinspired design of AgNPs embedded silk sericin-based sponges for efficiently combating bacteria and promoting wound healing. Mater. Des. 2019, 180, 107940. [Google Scholar] [CrossRef]
- Mortimer, B.; Holland, C.; Vollrath, F. Forced Reeling of Bombyx mori Silk: Separating Behavior and Processing Conditions. Biomacromolecules 2013, 14, 3653–3659. [Google Scholar] [CrossRef]
- Aramwit, P.; Kanokpanont, S.; Nakpheng, T.; Srichana, T. The Effect of Sericin from Various Extraction Methods on Cell Viability and Collagen Production. Int. J. Mol. Sci. 2010, 11, 2200–2211. [Google Scholar] [CrossRef]
- Lawrence, B.D.; Marchant, J.K.; Pindrus, M.A.; Omenetto, F.G.; Kaplan, D.L. Silk film biomaterials for cornea tissue engineering. Biomaterials 2009, 30, 1299–1308. [Google Scholar] [CrossRef]
- Song, Y.; Zhang, C.; Zhang, J.; Sun, N.; Huang, K.; Li, H.; Wang, Z.; Huang, K.; Wang, L. An injectable silk sericin hydrogel promotes cardiac functional recovery after ischemic myocardial infarction. Acta Biomater. 2016, 41, 210–223. [Google Scholar] [CrossRef]
- Mortimer, B.; Gordon, S.D.; Holland, C.; Siviour, C.R.; Vollrath, F.; Windmill, J.F. The speed of sound in silk: Linking material performance to biological function. Adv. Mater. 2014, 26, 5179–5183. [Google Scholar] [CrossRef]
- Sparkes, J.; Holland, C. The rheological properties of native sericin. Acta Biomater. 2018, 69, 234–242. [Google Scholar] [CrossRef]
- Falanga, V. Wound healing and its impairment in the diabetic foot. Lancet 2005, 366, 1736–1743. [Google Scholar] [CrossRef]
- Sun, G.; Zhang, X.; Shen, Y.I.; Sebastian, R.; Dickinson, L.E.; Fox-Talbot, K.; Reinblatt, M.; Steenbergen, C.; Harmon, J.W.; Gerecht, S. Dextran hydrogel scaffolds enhance angiogenic responses and promote complete skin regeneration during burn wound healing. Proc. Natl. Acad. Sci. USA 2011, 108, 20976–20981. [Google Scholar] [CrossRef]
- Xi, Y.; Ge, J.; Guo, Y.; Lei, B.; Ma, P.X. Biomimetic Elastomeric Polypeptide-Based Nanofibrous Matrix for Overcoming Multidrug-Resistant Bacteria and Enhancing Full-Thickness Wound Healing/Skin Regeneration. ACS Nano 2018, 12, 10772–10784. [Google Scholar] [CrossRef]
- Yang, M.; Shuai, Y.; Zhou, G.; Mandal, N.; Zhu, L.; Mao, C. Tuning Molecular Weights of Bombyx mori (B. mori) Silk Sericin to Modify Its Assembly Structures and Materials Formation. ACS Appl. Mater. Interfaces 2014, 6, 13782–13789. [Google Scholar] [CrossRef]
- Lin, S.; Liu, X.; Liu, J.; Yuk, H.; Loh, H.-C.; Parada, G.A.; Settens, C.; Song, J.; Masic, A.; McKinley, G.H.; et al. Anti-fatigue-fracture hydrogels. Sci. Adv. 2019, 5, eaau8528. [Google Scholar] [CrossRef]
- Tao, G.; Wang, Y.; Cai, R.; Chang, H.; Song, K.; Zuo, H.; Zhao, P.; Xia, Q.; He, H. Design and performance of sericin/poly (vinyl alcohol) hydrogel as a drug delivery carrier for potential wound dressing application. Mater. Sci. Eng. C 2019, 101, 341–351. [Google Scholar] [CrossRef]
- Gilotra, S.; Chouhan, D.; Bhardwaj, N.; Nandi, S.K.; Mandal, B.B. Potential of silk sericin based nanofibrous mats for wound dressing applications. Mater. Sci. Eng. C 2018, 90, 420–432. [Google Scholar] [CrossRef]
- Sharifi, S.; Behzadi, S.; Laurent, S.; Forrest, M.L.; Stroeve, P.; Mahmoudi, M. Toxicity of nanomaterials. Chem. Soc. Rev. 2012, 41, 2323–2343. [Google Scholar] [CrossRef]
- Li, X.; Weng, Y.; Kong, X.; Zhang, B.; Li, M.; Diao, K.; Zhang, Z.; Wang, X.; Chen, H. A covalently crosslinked polysaccharide hydrogel for potential applications in drug delivery and tissue engineering. J. Mater. Sci. Mater. Med. 2012, 23, 2857–2865. [Google Scholar] [CrossRef]
- Hameed, A.S.H.; Karthikeyan, C.; Ahamed, A.P.; Thajuddin, N.; Alharbi, N.S.; Alharbi, S.A.; Ravi, G. In vitro antibacterial activity of ZnO and Nd doped ZnO nanoparticles against ESBL producing Escherichia coli and Klebsiella pneumoniae. Sci. Rep. 2016, 6, 24312–24323. [Google Scholar] [CrossRef]
- Stoimenov, P.K.; Klinger, R.L.; Marchin, G.L.; Klabunde, K.J. Metal Oxide Nanoparticles as Bactericidal Agents. Langmuir 2002, 18, 6679–6686. [Google Scholar] [CrossRef]
- Zhang, Y.; Gu, A.Z.; Xie, S.; Li, X.; Cen, T.; Li, D.; Chen, J. Nano-metal oxides induce antimicrobial resistance via radical-mediated mutagenesis. Environ. Int. 2018, 121, 1162–1171. [Google Scholar] [CrossRef]
- Dayakar, T.; Rao, K.V.; Bikshalu, K.; Rajendar, V.; Park, S.H. Novel synthesis and structural analysis of zinc oxide nanoparticles for the non enzymatic glucose biosensor. Mater. Sci. Eng. C Mater. Biol. Appl. 2017, 75, 1472–1479. [Google Scholar] [CrossRef]
- Aswan, A.A.; Jing, F.; Doran, P.M.; Tan, T.T.Y.; Chan, P.P.Y. InjecTable 3D hydrogel scaffold with tailorable porosity post-implantation. Adv. Healthc. Mater. 2014, 3, 725–736. [Google Scholar]
- Cao, T.T.; Zhang, Y.Q. Processing and characterization of silk sericin from Bombyx mori and its application in biomaterials and biomedicines. Mater. Sci. Eng. C Mater. Biol. Appl. 2016, 61, 940–952. [Google Scholar] [CrossRef]
- Wang, Z.; Zhang, Y.; Zhang, J.; Huang, L.; Liu, J.; Li, Y.; Zhang, G.; Kundu, S.C.; Wang, L. Exploring natural silk protein sericin for regenerative medicine: An injectable, photoluminescent, cell-adhesive 3D hydrogel. Sci. Rep. 2014, 4, 7064–7075. [Google Scholar] [CrossRef]
- Bagheri, M.; Rabieh, S. Preparation and characterization of cellulose-ZnO nanocomposite based on ionic liquid ([C(4)mim]Cl). Cellulose 2013, 20, 699–705. [Google Scholar] [CrossRef]
- Teramoto, H.; Miyazawa, M. Molecular orientation behavior of silk sericin film as revealed by ATR infrared spectroscopy. Biomacromolecules 2005, 6, 2049–2057. [Google Scholar] [CrossRef]
- Singh, B.N.; Panda, N.N.; Mund, R.; Pramanik, K. Carboxymethyl cellulose enables silk fibroin nanofibrous scaffold with enhanced biomimetic potential for bone tissue engineering application. Carbohydr. Polym. 2016, 151, 335–347. [Google Scholar] [CrossRef]
- Zhang, X.M.; Wyeth, P. Using FTIR spectroscopy to detect sericin on historic silk. Sci. China Chem. 2010, 53, 626–631. [Google Scholar] [CrossRef]
- Kundu, J.; Mohapatra, R.; Kundu, S.C. Silk fibroin/sodium carboxymethylcellulose blended films for biotechnological applications. J. Biomater. Sci. Polym. Ed. 2011, 22, 519–539. [Google Scholar] [CrossRef]
- Wang, Y.W.; Cao, A.; Jiang, Y.; Zhang, X.; Liu, J.H.; Liu, Y.; Wang, H. Superior antibacterial activity of zinc oxide/graphene oxide composites originating from high zinc concentration localized around bacteria. ACS Appl. Mater. Interfaces 2014, 6, 2791–2798. [Google Scholar] [CrossRef]
- Yang, H.; Yang, S.; Kong, J.; Dong, A.; Yu, S. Obtaining information about protein secondary structures in aqueous solution using Fourier transform IR spectroscopy. Nat. Protoc. 2015, 10, 382–396. [Google Scholar] [CrossRef]
- Teramoto, H.; Miyazawa, M. Analysis of Structural Properties and Formation of Sericin Fiber by Infrared Spectroscopy. J. Insect Biotechnol. Sericol. 2003, 72, 157–162. [Google Scholar] [CrossRef]
- Žūkienė, R.; Snitka, V. Zinc oxide nanoparticle and bovine serum albumin interaction and nanoparticles influence on cytotoxicity in vitro. Colloids Surf. B Biointerfaces 2015, 135, 316–323. [Google Scholar] [CrossRef]
- Kadiyala, U.; Turali-Emre, E.S.; Bahng, J.H.; Kotov, N.A.; Vanepps, J.S. Unexpected insights into antibacterial activity of zinc oxide nanoparticles against methicillin resistant Staphylococcus aureus (MRSA). Nanoscale 2018, 10, 4927–4939. [Google Scholar] [CrossRef]
- Seil, J.T.; Webster, T.J. Reduced Staphylococcus aureus proliferation and biofilm formation on zinc oxide nanoparticle PVC composite surfaces. Acta Biomater. 2011, 7, 2579–2584. [Google Scholar] [CrossRef]
- Kundu, B.; Kundu, S.C. Silk sericin/polyacrylamide in situ forming hydrogels for dermal reconstruction. Biomaterials 2012, 33, 7456–7467. [Google Scholar] [CrossRef]
- Nayak, S.; Dey, T.; Naskar, D.; Kundu, S.C. The promotion of osseointegration of titanium surfaces by coating with silk protein sericin. Biomaterials 2013, 34, 2855–2864. [Google Scholar] [CrossRef]
- Ai, L.; Wang, Y.; Tao, G.; Zhao, P.; Umar, A.; Wang, P.; He, H. Polydopamine-Based Surface Modification of ZnO Nanoparticles on Sericin/Polyvinyl Alcohol Composite Film for Antibacterial Application. Molecules 2019, 24, 503. [Google Scholar] [CrossRef]
- Aghaz, F.; Hajarian, H.; KaramiShabankareh, H. In vitro culture medium (IVC) supplementation with sericin improves developmental competence of ovine zygotes. Reprod. Biol. 2016, 16, 87–90. [Google Scholar] [CrossRef]
- Wang, Y.; Cai, R.; Tao, G.; Wang, P.; Zuo, H.; Zhao, P.; Umar, A.; He, H. A novel AgNPs/sericin/agar film with enhanced mechanical property and antibacterial capability. Molecules 2018, 23, 1821. [Google Scholar] [CrossRef]
- Tavsanli, B.; Okay, O. Mechanically robust and stretchable silk/hyaluronic acid hydrogels. Carbohydr. Polym. 2019, 208, 413–420. [Google Scholar] [CrossRef]
- Zhang, Y.; Liu, J.; Huang, L.; Wang, Z.; Wang, L. Design and performance of a sericin-alginate interpenetrating network hydrogel for cell and drug delivery. Sci. Rep. 2015, 5, 12374–12387. [Google Scholar] [CrossRef]
- Zhang, L.; Yang, W.; Tao, K.; Song, Y.; Xie, H.; Wang, J.; Li, X.; Shuai, X.; Gao, J.; Chang, P.; et al. Sustained Local Release of NGF from a Chitosan-Sericin Composite Scaffold for Treating Chronic Nerve Compression. ACS Appl. Mater. Interfaces 2017, 9, 3432–3444. [Google Scholar] [CrossRef]
- Kumar, A.; Rao, K.M.; Han, S.S. Synthesis of mechanically stiff and bioactive hybrid hydrogels for bone tissue engineering applications. Chem. Eng. J. 2017, 317, 119–131. [Google Scholar] [CrossRef]
- Lee, D.H.; Tripathy, N.; Shin, J.H.; Song, J.E.; Cha, J.G.; Min, K.D.; Chan, H.P.; Khang, G. Enhanced Osteogenesis of β-Tricalcium Phosphate Reinforced Silk Fibroin Scaffold for Bone Tissue Biofabrication. Int. J. Biol. Macromol. 2016, 95, 14–23. [Google Scholar] [CrossRef]
- Li, D.; Ye, Y.; Li, D.; Li, X.; Mu, C. Biological properties of dialdehyde carboxymethyl cellulose crosslinked gelatin-PEG composite hydrogel fibers for wound dressings. Carbohydr. Polym. 2016, 137, 508–514. [Google Scholar] [CrossRef]
- Sukdeb, P.; Kyung, T.Y.; Joon Myong, S. Does the antibacterial activity of silver nanoparticles depend on the shape of the nanoparticle? A study of the Gram-negative bacterium Escherichia coli. Appl. Environ. Microbiol. 2007, 73, 1712–1720. [Google Scholar]

© 2019 by the authors. Licensee MDPI, Basel, Switzerland. This article is an open access article distributed under the terms and conditions of the Creative Commons Attribution (CC BY) license (http://creativecommons.org/licenses/by/4.0/).
Share and Cite
Ai, L.; He, H.; Wang, P.; Cai, R.; Tao, G.; Yang, M.; Liu, L.; Zuo, H.; Zhao, P.; Wang, Y. Rational Design and Fabrication of ZnONPs Functionalized Sericin/PVA Antimicrobial Sponge. Int. J. Mol. Sci. 2019, 20, 4796. https://doi.org/10.3390/ijms20194796
Ai L, He H, Wang P, Cai R, Tao G, Yang M, Liu L, Zuo H, Zhao P, Wang Y. Rational Design and Fabrication of ZnONPs Functionalized Sericin/PVA Antimicrobial Sponge. International Journal of Molecular Sciences. 2019; 20(19):4796. https://doi.org/10.3390/ijms20194796
Chicago/Turabian StyleAi, Lisha, Huawei He, Peng Wang, Rui Cai, Gang Tao, Meirong Yang, Liying Liu, Hua Zuo, Ping Zhao, and Yejing Wang. 2019. "Rational Design and Fabrication of ZnONPs Functionalized Sericin/PVA Antimicrobial Sponge" International Journal of Molecular Sciences 20, no. 19: 4796. https://doi.org/10.3390/ijms20194796
APA StyleAi, L., He, H., Wang, P., Cai, R., Tao, G., Yang, M., Liu, L., Zuo, H., Zhao, P., & Wang, Y. (2019). Rational Design and Fabrication of ZnONPs Functionalized Sericin/PVA Antimicrobial Sponge. International Journal of Molecular Sciences, 20(19), 4796. https://doi.org/10.3390/ijms20194796




